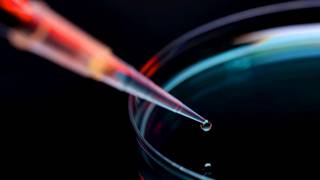
Die steigende Dividende für 2018 ist nur ein Trostpflaster für Covestro-Aktionäre, die sich 2019 auf einen deutlich fallenden operativen Gewinn einstellen müssen. Bild und Copyright: Covestro.

Covestro: Neue Gewinnerwartungen

Mit den Zahlen zum vierten Quartal und zum Gesamtjahr bei Covestro kann man nicht wirklich zufrieden sein, sie verfehlen die Erwartungen. Allerdings verdient die Dividende eine lobende Erwähnung. Covestro will eine Dividende von 2,40 Euro je Aktie ausschütten. Die Experten von Independent Research waren von 2,20 Euro ausgegangen. Sie bestätigen in ihrer heutigen Studie die Halteempfehlung für die Aktien von Covestro. Das Kursziel für die Covestro-Aktien sehen die Experten bei 52,00 Euro. Bisher lag es bei 53,00 Euro.
Bei der Konjunktur könnte es eine Abschwächung geben, darauf deuten die Frühindikatoren hin. Das lassen die Experten in ihr Modell einfließen. Sie rechnen für 2019 mit einem Gewinn je Aktie von 3,53 Euro (alt: 7,89 Euro). Die Prognose für 2020 steigt von 5,12 Euro auf 5,39 Euro an. Die Dividende soll dann bei 2,45 Euro. Die Dividendenrendite liegt bei 4,7 Prozent.
Die Aktien von Covestro verlieren am Mittag 4,0 Prozent auf 49,51 Euro.
Dieser Bericht könnte Sie auch interessieren
Dieser Bericht könnte Sie auch interessieren


